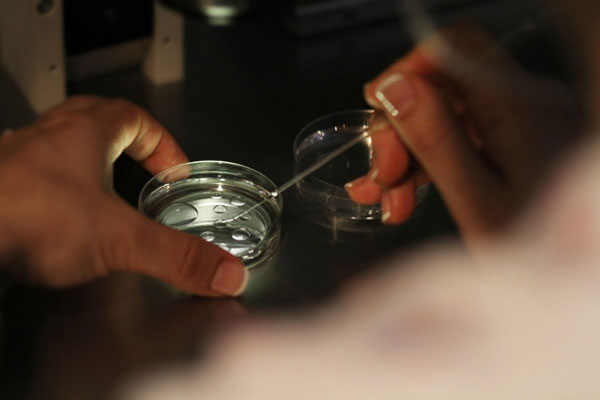
人工授精能不能生男孩？人工授精男孩女孩比例

-
关于人工授精的那些事儿
◆◆人工授精的分类◆◆人工授精根据精液来源、储存方法、授精部位的不同有不同的分类。(一)根据所用精液来源的不同分为三类1.夫精人工授精夫精人工授精(AIH) 是使用..
2022-10-27 13:50 -

人工授精助孕成功率高吗
做人工授精的人都十分关心成功率的问题,很多人都会问“人工授精的成功率高吗?”1.人工授精的成功率人工授精的成功率大概在25%左右,每个患者的身体状况不同,身体状况较..
2022-11-27 09:13 -

人工授精的成功率大概是多少
人工授精怀孕成功率不到10%据介绍,目前广东省大概有几十家医院或相关机构在开展人工授精技术,但总体而言,它带来的怀孕率仍然偏低。通过这种方式怀孕的不到10%,而如果夫..
2022-11-30 09:10 -

沈阳做人工授精的费用真不高,单个周期仅需几千元别担心
沈阳目前有8家医院可以开展辅助生殖技术,并且基本上每家医院都可以进行人工授精技术。但是需要知道的额是,每家医院的成功率和费用是存在一定区别的。在沈阳单个周期的人..
2022-12-11 13:08 -

二胎是先做人工授精好还是直接试管婴儿好?
二胎是先做人工授精好还是直接试管婴儿好?通常情况下,与试管婴儿相比,人工授精对夫妻双方的伤害较小,操作简单,费用较低。所以建议准备生二胎的家庭先做人工授精。当然..
2022-12-11 16:05 -

金华可以做人工授精的医院汇总,对比成功率就知选哪家好
据了解,浙江省目前能够开展辅助生殖技术的医院一共有27家,大多数的都集中在杭州,金华只有2家。虽然说金华只有两家医院能够开展辅助生殖技术,但是其开展的项目还是比较..
2022-12-14 13:03 -

人工授精老公需要去医院千万别忘记,要去几次因人而异
随着现在医疗技术的逐渐成熟,越来越多的不孕不育患者都能够通过治疗实现生育的愿望,其中人工授精就是大多数不孕患者的选择。人工授精是目前比较接近自然受孕的一项技术,..
2022-12-24 13:10 -

四川人工授精最好的医院(成都五医院人工授精成功)
2月2日大年初二,在成都市第五人民医院妇产科—生殖医学中心团队的努力下,年过30的王女士通过人工授精方式成功怀孕并顺利分娩一女,圆了王女士多年的“母亲梦”。这也是成..
2023-01-10 09:04 -

人工授精费用大概要多少钱(人工授精的优缺点)
什么是人工授精?人工授精授是指在女性排卵日将优化处理过的精子送入女性子宫腔内,其特点在于优化和导入。优化是指筛选出好的,在几亿个精子中优选出数百万个精英;导入是..
2023-02-08 09:14 -
人工授精能不能生男孩?人工授精男孩女孩比例
随着医学技术的发展,不孕不育人群迎来了新的希望,人们不再满足于用老方法生儿育女,而想要实现优生优育,甚至还想通过辅助生殖技术选择性别,按照自己的需求来怀宝宝。人..
2023-03-01 12:19 -

详细解读人工授精的全过程,是不是用针管注射清清楚楚
拥有一个健康、可爱的宝宝是大多数家庭的愿望,但是现在随着社会的发展、生活环境的改变以及人们生育观念的改变,生育成为了不少家庭的难题。针对由于各种原因无法成功怀孕..
2023-03-04 13:18 -

一文解读南京妇幼保健院申请做供精人工授精要排队时间,最快1-3个月
当男性的精子质量差、精子畸形率高等因素导致不孕不育的情况下,那么就可以考虑做供精人工授精来进行助孕了,但需要夫妻双方进行协商好。接下来是由石河子妇幼网整理的一份..
2023-03-05 10:04 -

做供精人工授精需要哪些证件手续?身份证、结婚证、出生证三证必不可少
供精人工授精虽然是一种生育的手段,但是并不是想做就能做的,需要达到一定的条件后经申请批准后才能到正规医院进行的,接下来是由石河子妇幼网整理的一份关于做供精人工授..
2023-03-05 10:10 -

成都做人工授精的费用真不贵,医保能否报销看看就知道
成都做人工授精的医院其实还是比较多的,能够通过非性交的方式帮助女性提高怀孕几率。人工受精的费用是不少患者非常好奇的,在成都做人工授精的费用大概是1万~2万元左右,..
2023-03-12 13:14 -

详细介绍2022成都人工授精费用,需要多少钱一目了然
近年来,不孕不育患者正在逐渐增多,不少幸福美满的家庭也因为不孕症而支离破碎。辅助生殖技术的出现帮助了很多不孕患者实现了生育的愿望,人工授精就是其中的一项技术。关..
2023-03-12 13:33 -

2022江苏供精人工授精医院名单,南京、苏州多家都能做
据了解就目前而言,江苏省一共有33家获批开展辅助生殖技术的医院。虽然说江苏省能够进行辅助生殖的医院有很多,但是每个医院所支持开展的技术都是不同的。整个江苏省只有6..
2023-03-16 13:21 -

杭州人工授精的费用明细表来了,做一次多少钱看完不迷茫
人工授精其实也是辅助生殖技术的一种,能够通过人工的方式帮助不孕不育夫妻实现生育的愿望。人工授精一般是采用非性交的方式将男性的精子注射到女性体内和卵子进行结合,是..
2023-03-17 13:19 -

人工授精顺利着床的表现整理:腰酸胀是成功症状要知道
人工授精也是一项辅助生殖技术,能够帮助患有不孕不育症的夫妻实现生育的目的。并且人工授精是目前比较常用的一种助孕方式,一般就是挑选一些活力比较好的精子移植到女性体..
2023-03-17 13:44 -

多囊医生建议人工授精的原因汇总,一般几次成功因人而异
众所周知,多囊是一种常见的妇科疾病,由于女性卵巢中的多个小卵泡无法正常生长发育为成熟卵泡,并且大多数患者还存在排卵障碍的情况,因此多囊是导致女性不孕的原因之一。..
2023-03-25 11:39 -
到底选择人工授精好还是试管好?看专家是怎么分析的
人工授精和试管婴儿各有优缺点,无法区别哪个更好。二者的适用的人群是不一样的,因此带来的效果和相应的成功率也会有差别,无法相提并论。人工授精适用于男方患有弱精少精..
2023-03-27 12:23
微信分享
扫描二维码分享到微信或朋友圈